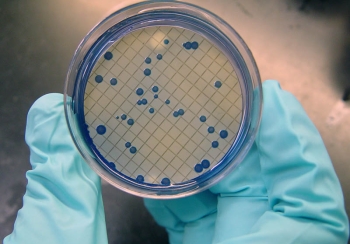

मान्म– पहिरोका कारण शनिबार बिहानदेखि अवरुद्ध भएको कर्णाली करिडोर आजदेखि सञ्चालन भएको छ । करिडोरअन्तर्गत जिल्लाको पचालझरना गाउँपालिका–८ लाफामा वर्षासँगै आएको पहिरोले कालीकोटको खुलालुदबाट हुम्ला जोड्न खण्ड अवरुद्ध भएको थियो ।
शनिबार बिहानदेखि अवरुद्ध भएको राजमार्ग प्रहरी, स्थानीय र जनप्रतिनिधिको पहलमा पहिरो पन्छाएर आज बिहानदेखि नियमित सञ्चालनमा आएको जिल्ला प्रहरी कार्यालयका प्रहरी प्रमुख अर्जुन केसीले जानकारी दिए । ‘लेदोसहित आएको पहिरोले शनिबारदेखि राजमार्ग अवरुद्ध भएको थियो’, उनले भने, ‘डोजर लगाएर प्रहरी र स्थानीयको पहलमा आज पहिरो पन्छाएपछि यातायातका साधन सञ्चालनमा आएका हुन् ।’
कर्णाली करिडोरमा वर्षायाममा बाढीपहिरोको निकै जोखिम हुने भएकाले उक्त राजमार्ग भएर स